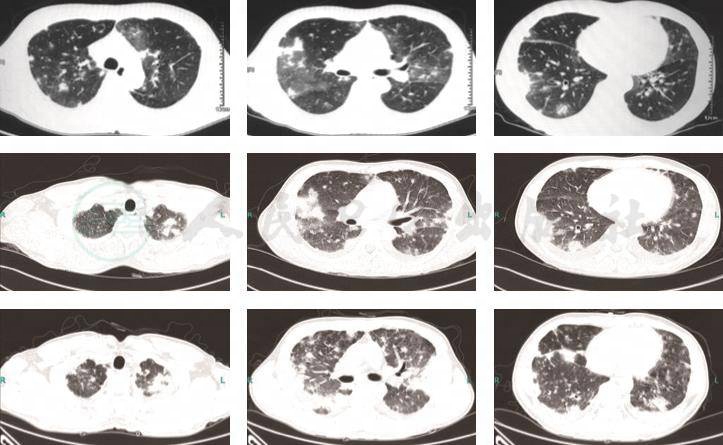

(一)一般资料
男性,38岁,江西宜春人,于2017年4月18日入住我院呼吸与危重症医学科。
(二)主诉
咳嗽、发热1月余,呼吸困难3天。
(三)现病史
患者2017年3月上旬无明显诱因出现咳嗽,呈阵发性干咳、无痰,有午后、夜间发热,体温最高39.8℃,不伴寒战、盗汗,无胸痛、腹痛、尿痛等不适。自行服用“复方感冒颗粒”后体温有下降,但仍有反复发热。2017年3月20日于当地人民医院就诊,行胸部CT等检查后诊断为“细菌性肺炎”,住院抗感染治疗(头孢哌酮舒巴坦),症状无明显改善。2017年4月6日转入我院急诊科完善相关检查,考虑:①肺部感染;②白细胞减少;③贫血原因待查,先后予以“拉氧头孢(疗程3天)、莫西沙星(疗程6天)”抗感染治疗。体温出现下降趋势,波动在36.5~37.5℃。2017年4月15日患者出现呼吸困难,活动后加重,可平卧,予以“左氧氟沙星联合卡泊芬净(疗程2天)”抗感染,输注浓缩红细胞纠正贫血等治疗,患者病情无明显好转。2017年4月18日转入呼吸ICU。起病以来,患者食欲、精神稍差,睡眠、大小便尚可,体重减轻5kg。
(四)既往史
2016年12月因双下肢小腿部皮肤病变,于当地医院就诊诊断为双下肢皮肤“脓肿”,予以切开引流后皮肤病变逐渐愈合。否认结核病及密切接触史。
(五)个人史
吸烟20余年,每日1包,偶有饮酒。
(一)体格检查
1.体温37.5℃,心率113次/min,呼吸25次/min,血压117/68mmHg。
2.急性病容,全身浅表淋巴结未触及明显肿大。
3.左侧面部可见2个约0.4cm×0.4cm丘疹,无红肿热痛,触之有液波感。
4.胸廓对称,双肺呼吸音粗,未闻及明显啰音。
5.心率113次/min,心律整齐,未闻及明显心音异常及心脏杂音。
6.双下肢皮肤可见多发瘢痕形成,未见杵状指/趾。
(二)实验室检查
1.血常规(2017年 4月 17日)WBC 2.8×109/L,Hb 67g/L,PLT 238×109/L,中性粒细胞百分比71%,尿常规正常;大便+OB阴性。
2.肝功能ALB 26.2g/L;肾功能正常;心肌酶无明显异常。
3.CRP 126mg/L,ESR 120mm/h;PCT 0.53ng/ml。
4.风湿、免疫全套、ANCA、血管炎三项、狼疮全套、ANA谱阴性;肿瘤7项阴性。
5.病毒全套、呼吸道九联检、巨细胞病毒DNA、寄生虫全套、结核抗体、结核T-SPOT、GM/G试验,输血前四项阴性。痰涂片抗酸染色、血培养阴性。
6.骨髓穿刺细胞学检查骨髓增生减低,粒系减低,红系增高,巨核细胞及血小板分布正常。
7.入院前3次胸部CT对比(2017年4月3日,2017年4月7日,2017年4月17日)双肺弥漫性病变,中外带病灶较前增多,考虑感染可能性大(图1)。
图1 胸部CT
(由上至下分别是2017年4月3日,2017年4月7日,2017年4月17日)
8.电子支气管镜检查示支气管炎症(图2),BALF细菌、真菌培养阴性。

图2 支气管镜检查
(一)病例特点回顾
1.青年男性,病程1月余,有发热,干咳,呼吸困难;既往有双下肢皮肤病变病史。
2.呼吸频率增快,贫血貌,面部有皮疹,双下肺少许湿性啰音。
3.Ⅰ型呼吸衰竭,白细胞减少,贫血,骨髓增生减低。CRP、ESR明显升高,PCT轻度升高。
4.肺部CT示双肺病变,多发结节及斑片渗出影,逐渐增多融合实变。
5.广谱抗细菌治疗肺部影像无吸收,使用莫西沙星抗感染治疗,体温疑似有下降趋势。
(二)诊断分析
总结该患者病例特点,青年男性,有发热、双肺病变,伴血液系统受累(白细胞、血红蛋白减低)。以发热、双肺病变及白细胞减少、贫血两个问题进行诊断分析(图3)。

图3 感染性和非感染性肺部疾病的鉴别诊断流程[1]
1.发热、双肺病变的诊断分析
(1)肺部感染性疾病
患者有发热、咳嗽、呼吸困难等呼吸系统表现,实验室检查提示炎症指标(CRP、ESR、PCT)升高,胸部CT见肺部斑片状渗出实变影。患者白细胞减少可能存在免疫力低下,不排除特殊病原体(结核、真菌)感染可能,需进一步寻找病原学证据,必要时行肺穿刺活检完善肺组织病理检查(特殊染色)、组织培养。
(2)非感染性病变
患者无咳痰,支气管镜检查未见化脓性炎症,经广谱抗生素(覆盖细菌)治疗后体温无明显下降趋势。结合患者胸部影像学特点,需要与机化性肺炎等非感染性病变鉴别。
2.白细胞减少、贫血的诊断分析
(1)血液系统疾病
考虑淋巴瘤、MDS可能,但暂无明显骨髓病态造血证据,需要进一步完善骨髓细胞染色体、骨髓基因检测,必要时行骨髓活检。
(2)非血液系统疾病
感染相关性白细胞减少、贫血?结缔组织疾病可以累及肺部及血液系统而出现发热、双肺病变及血细胞减少等,但患者暂无特征性自身抗体阳性,系统性红斑狼疮、系统性血管炎等依据不足。
(一)进一步检查及追问病史
1.CT引导下经皮肺穿刺活检病理(图4) (右肺上叶)送检肺穿刺组织2条,肺泡结构存在,肺泡隔增宽并纤维化,肺泡腔内较多纤维样物质渗出,并早期机化改变,另见少量淋巴细胞及巨噬细胞,未见肉芽肿性病变,倾向炎性病变并早期机化。特殊染色结果:抗酸染色(-),PAS(-),氯氨银染色(-)。

图4 肺穿刺活检组织病理
2.肺穿刺活检组织培养阴性。
3.骨髓染色体、基因检查 骨髓FISH:7q-,+8。TCRB基因存在缺失现象。骨髓染色体结果回报6个分裂象均可见+8。
4.追问病史 2016年8月患者于当地医院查血常规发现贫血(贫血病史半年以上)。患者2016年12月因双下肢小腿部皮肤脓肿于当地医院行切开引流,病理检查结果提示真皮层大量中性粒细胞浸润。
(二)诊治过程
1.入院后改用莫西沙星联合伏立康唑或卡泊芬净(4月18日~5月1日)抗细菌、真菌治疗,4月22日~5月1日诊断性抗结核治疗(异烟肼、利福平、乙胺丁醇、吡嗪酰胺)。间断输入同型浓缩红细胞纠正贫血。患者仍有发热,呼吸困难进一步加重,5月4日复查胸部CT示双肺病变较前进一步加重(图5)。
2.5月4日肺穿刺活检病理结果回报考虑机化性肺炎,开始予以甲泼尼龙(80mg/d×3天后改为40mg/d维持)抗感染治疗,同时停用抗真菌治疗。患者体温逐渐下降至正常(5月7日体温恢复正常),呼吸困难症状好转。5月15日(激素治疗10天)复查胸部CT示双肺病灶较前明显吸收好转(图5)。
(三)随访
患者2017年6月复查胸部CT示双肺病变进一步吸收好转。

图5 胸部CT
(由上至下分别是2017年5月4日,2017年5月15日)
(一)最后诊断
1.MDS
2.继发性机化性肺炎
3.Ⅰ型呼吸衰竭
4.Sweet综合征?
5.贫血
(二)诊断依据
1.青年男性,既往2016年血常规提示贫血(病史半年以上),实验室检查有白细胞减少、贫血,骨髓染色体及骨髓基因检测均提示7号染色体长臂缺失(7q-)和8号染色体三体(+8),考虑MDS诊断成立。
2.患者有干咳、发热、呼吸困难呼吸系统症状,胸部CT示肺野外带胸膜下分布为主的斑片状渗出、实变影。肺穿刺活检病理提示肺泡腔多纤维样物质渗出,并早期机化改变。经甲泼尼龙抗感染治疗后双肺病变较前明显吸收好转。综合患者胸部影像学特点及肺组织活检病理结果考虑机化性肺炎诊断成立。
3.患者2016年12月双下肢皮肤病变,病理提示真皮层大量中性粒细胞浸润,结合患者MDS诊断考虑Sweet综合征可能[2]。
1.发热并双肺病变常见于感染性病变,但同时也需要与非感染性病变相鉴别。本病例中患者双肺病变经广谱抗感染治疗无效,需要考虑非感染性病变,结合双肺病变影像学特点(肺野外带胸膜下分布为主的斑片状渗出、实变影)及肺穿刺活检病理进一步确诊为机化性肺炎。但在临床中MDS患者双肺病变多为感染性病变,合并机化性肺炎(非感染性病变)不多见。追问病史该患者出现呼吸系统症状前有皮肤受累表现,病变皮肤活检病理提示大量中性粒细胞浸润真皮层,考虑皮肤病变为MDS继发出现的Sweet综合征所致可能。结合文献中的病例报道,Sweet综合征常继发于肿瘤(特别是血液系统肿瘤),如同时又有肺部病变,需要考虑到机化性肺炎可能。
2.患者在MDS基础上出现机化性肺炎[3],我们应该尽量寻求用一元论来解释,通过追问病史及既往重要检查结果,查阅文献推导患者存在Sweet综合征,进一步揭示疾病真相,并经过逻辑推导验证诊断是否可解释疾病过程全貌,避免漏诊或误诊。
(杨 威)
[1]发热伴肺部阴影鉴别诊断共识专家组.发热伴肺部阴影鉴别诊断共识专家组.中华结核和呼吸杂志,2016,39(3):169-176.
[2]TZELEPIS E,KAMPOLIS F,VLACHADAMI I,et al. Cryptogenic organizing pneumonia in Sweet’s syndrome: case report and review of the literature. The Clinical Respiratory Journal,2014,10(2): 250-254.
[3]GARG RAJEEV,SOUD YOUSSEF,LAL RAJIV,et al. Myelodysplastic syndrome manifesting as Sweet’s syndrome and bronchiolitis obliterative organizing pneumonia. The American Journal of Medicine,2006,119(11):e5-e7.













